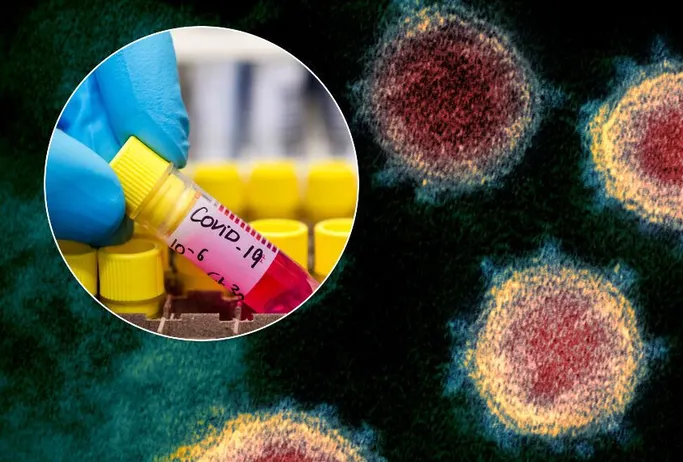

Степанов назвав групи людей, яких вакцинують першими від Covid-19
У пріоритеті першого етапу щеплення — працівники галузі охорони здоров’я, зазначив Степанов. Міністр охорони здоров’я України Максим…

У пріоритеті першого етапу щеплення — працівники галузі охорони здоров’я, зазначив Степанов. Міністр охорони здоров’я України Максим…

В Україні розпочалась вакцинація від грипу. До епідемічного сезону 2020-2021 років у країну поставили 665 тисяч доз…
Поява вакцини від коронавірусу може збігтися у часі із спадом захворюваності на COVID-19. Про це в ефірі…

Голова політради партії ОПЗЖ Віктор Медведчук зустрівся з президентом Росії Володимиром Путіним Про це повідомляє ТАСС. “Дуже раді,…

Новий календар щеплень України, затверджений МОЗ, діє з 18 квітня 2018 року. Дітям, які, згідно з ним, не пройшли…

Намір Росії впровадити частково ефективну вакцину проти COVID-19 “Супутник-V” до проведення її повних випробувань може спровокувати мутацію…